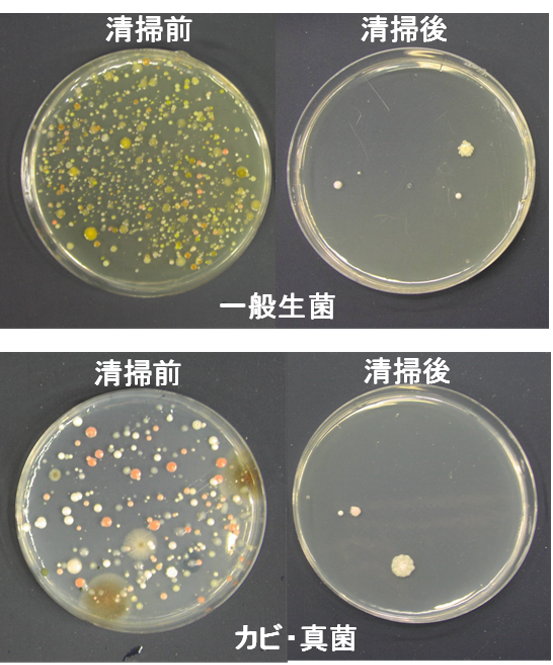

테이블 테스트로 사전에 효과를 확인!
도입전에 귀사의 사용 방법에 맞추어 폐사내의 랩에서 살균 시험을 실시해, 그 결과를 바탕으로 사용 방법을 제안합니다.
위생 관리 업무 30년의 실적이 있습니다. 식재료 살균 뿐만이 아니라, 위생 관리 수법이나 HACCP에 대해서도 부담없이 상담해 주세요.
폐사내에 실험실을 가지고 있기 때문에, 식재 살균이나 환경 소독의 검증에 대해서, 섬세한 대응이 가능합니다. 차아염소산의 활용을 견인합니다.
차아염소산을 이용한 위생 관리 업무에 30년의 실적이 있습니다.식재 살균 뿐만이 아니라, 위생 관리 수법이나 HACCP에 대해서도 부담없이 상담해 주세요.
| 스테인레스 스틸 리토리 (0) | 2025.03.10 |
|---|---|
| Securmax 320 MDP (0) | 2025.03.10 |
| 리프트 매트 (0) | 2025.03.10 |
| 스텝 매트 (0) | 2025.03.10 |
| 피그 그리피 플로어 매트 (0) | 2025.03.09 |